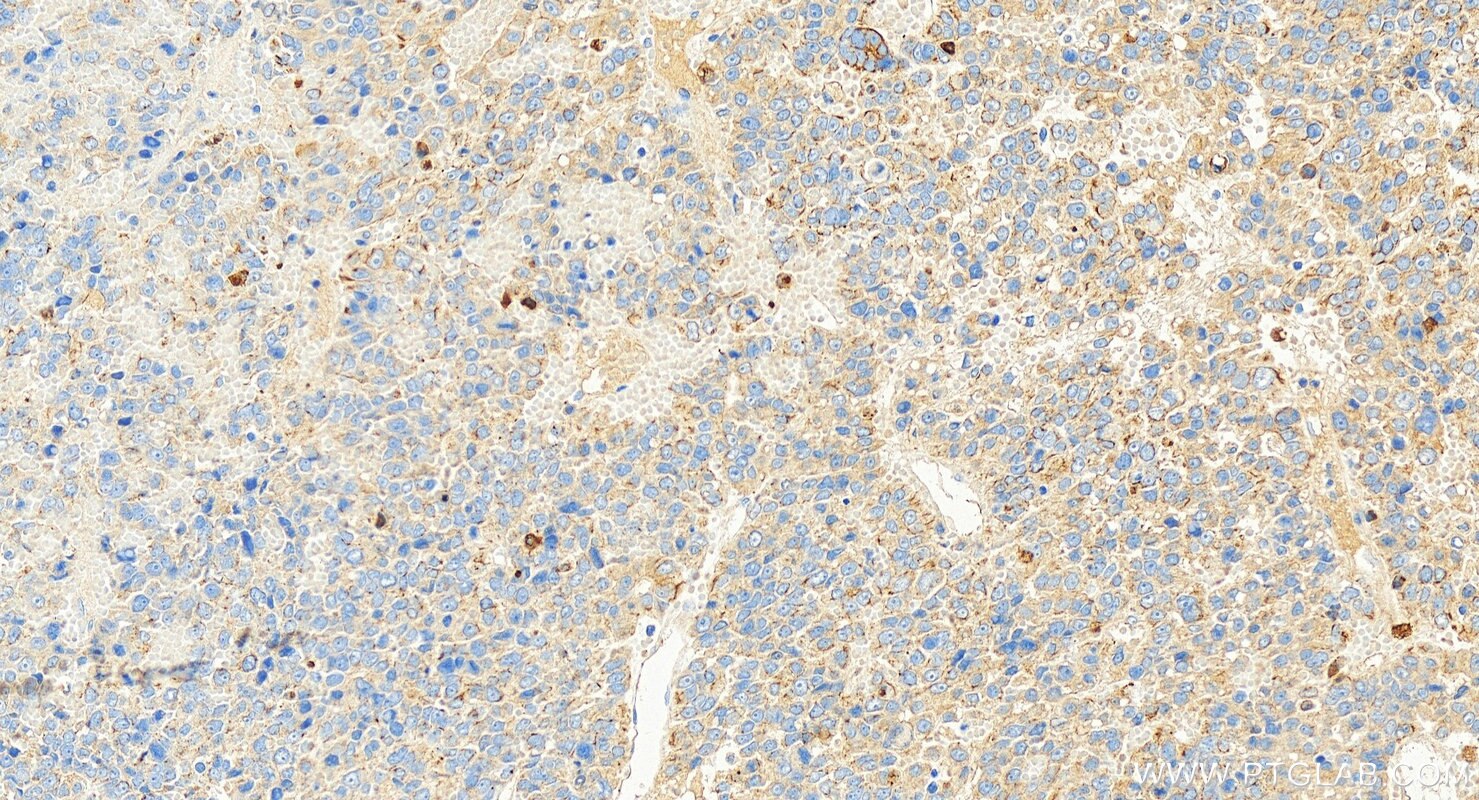
Immunohistochemical analysis of paraffin-embedded human hepatocellular carcinoma slide using 68627-1-Ig (Cytokeratin 8 antibody) at dilution of 1:1000 (under 20x lens). Heat mediated antigen retrieval with Tris-EDTA buffer (pH 9.0). Immunohistochemistry (IHC) staining of human hepatocellular carcinoma using Cytokeratin 8 Monoclonal antibody (68627-1-Ig)

Validation Data Gallery
Tested Applications
| Positive WB detected in | MCF-7 cells, A549 cells, rat colon tissue, mouse colon tissue, T-47D cells, SK-BR-3 cells, SW480 cells, HT-29 cells |
| Positive IHC detected in | human colon tissue, human hepatocellular carcinoma, human tonsillitis tissue Note: suggested antigen retrieval with TE buffer pH 9.0; (*) Alternatively, antigen retrieval may be performed with citrate buffer pH 6.0 |
Recommended dilution
| Application | Dilution |
|---|---|
| Western Blot (WB) | WB : 1:5000-1:50000 |
| Immunohistochemistry (IHC) | IHC : 1:250-1:1000 |
| It is recommended that this reagent should be titrated in each testing system to obtain optimal results. | |
| Sample-dependent, Check data in validation data gallery. | |
Product Information
68627-1-Ig targets Cytokeratin 8 in WB, IHC, ELISA applications and shows reactivity with human, mouse, rat samples.
| Tested Reactivity | human, mouse, rat |
| Host / Isotype | Mouse / IgG1 |
| Class | Monoclonal |
| Type | Antibody |
| Immunogen |
CatNo: Ag0488 Product name: Recombinant human KRT8 protein Source: e coli.-derived, PGEX-4T Tag: GST Domain: 1-483 aa of BC000654 Sequence: MSIRVTQKSYKVSTSGPRAFSSRSYTSGPGSRISSSSFSRVGSSNFRGGLGGGYGGASGMGGITAVTVNQSLLSPLVLEVDPNIQAVRTQEKEQIKTLNNKFASFIDKVRFLEQQNKMLETKWSLLQQQKTARSNMDNMFESYINNLRRQLETLGQEKLKLEAELGNMQGLVEDFKNKYEDEINKRTEMENEFVLIKKDVDEAYMNKVELESRLEGLTDEINFLRQLYEEEIRELQSQISDTSVVLSMDNSRSLDMDSIIAEVKAQYEDIANRSRAEAESMYQIKYEELQSLAGKHGDDLRRTKTEISEMNRNISRLQAEIEGLKGQRASLEAAIADAEQRGELAIKDANAKLSELEAALQRAKQDMARQLREYQELMNVKLALDIEIATYRKLLEGEESRLESGMQNMSIHTKTTSGYAGGLSSAYGGLTSPGLSYSLGSSFGSGAGSSSFSRTSSSRAVVVKKIETRDGKLVSESSDVLPK 相同性解析による交差性が予測される生物種 |
| Full Name | keratin 8 |
| Calculated molecular weight | 54 kDa |
| Observed molecular weight | 50-52 kDa |
| GenBank accession number | BC000654 |
| Gene Symbol | Cytokeratin 8 |
| Gene ID (NCBI) | 3856 |
| RRID | AB_3085319 |
| Conjugate | Unconjugated |
| Form | |
| Form | Liquid |
| Purification Method | Protein G purification |
| UNIPROT ID | P05787 |
| Storage Buffer | PBS with 0.02% sodium azide and 50% glycerol{{ptg:BufferTemp}}7.3 |
| Storage Conditions | Store at -20°C. Stable for one year after shipment. Aliquoting is unnecessary for -20oC storage. |
Background Information
Keratins are a large family of proteins that form the intermediate filament cytoskeleton of epithelial cells, which are classified into two major sequence types. Type I keratins are a group of acidic intermediate filament proteins, including K9-K23, and the hair keratins Ha1-Ha8. Type II keratins are the basic or neutral courterparts to the acidic type I keratins, including K1-K8, and the hair keratins, Hb1-Hb6. KRT8 is often paired with keratin 18 in vivo.
Protocols
| Product Specific Protocols | |
|---|---|
| IHC protocol for Cytokeratin 8 antibody 68627-1-Ig | Download protocol |
| WB protocol for Cytokeratin 8 antibody 68627-1-Ig | Download protocol |
| Standard Protocols | |
|---|---|
| Click here to view our Standard Protocols |